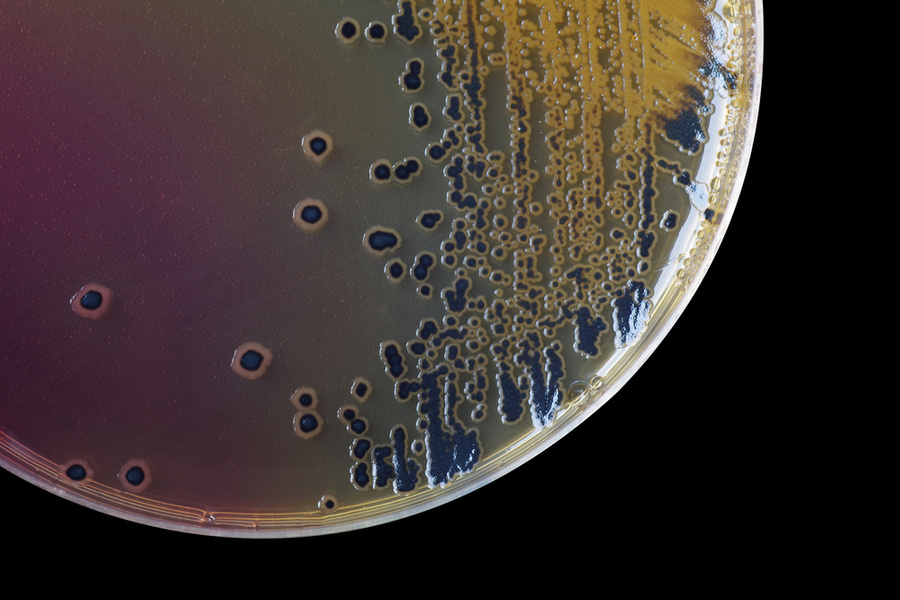
Бактерии Shigella. Фото © Shutterstock

Роспотребнадзор, Счётная палата и, наконец, Следственный комитет пытаются ответить на вопрос, интересующий всех россиян: что льётся из крана?
Водопад Тобот — природная достопримечательность и гордость Дагестана. Но за пределами республики о нём знают немногие. А вот о том, что в расположенном в таких красивых местах селе Арани отравились и даже заразились серьёзной инфекцией несколько десятков детей, узнала на днях вся страна. , в общей сложности 95 человек обратились к врачам, в том числе 65 детей. Самые частые симптомы — рвота и диарея.

Водопад Тобот в Дагестане. Фото © Google Maps
— Роспотребнадзором Республики Дагестан установлен водный путь передачи инфекции, возбудителем которой являются шигеллы дизентерии, — республиканский Минздрав.
Как рассказал местным СМИ глава поселения, Арани снабжается водой из естественного источника с помощью водоводов
Любопытно, что, по данным на сайтах закупок, осенью 2020 года был объявлен тендер на выбор поставщика услуги "Водоснабжение с. Арани Хунзахского района". В графе "Наименование позиции" значится: "Работы строительные по строительству оросительных систем (каналов), водоводов и водоводных конструкций, водоочистных станций, станций очистки сточных вод и насосных станций". Похоже, конкурс не состоялся, по крайней мере, победителя не объявили. А меж тем местные жители говорят, что точно такая же вспышка у них была в 2018 году.
Не далее как в январе 2021 года бактерии Shigella вкупе с Campylobacter (тоже возбудитель кишечной инфекции) водопроводной воды и в анализах заболевших в Буйнакске. Примечательно, что большинство госпитализированных там тоже дети. Примерно в то же время в Кизляре, после этого местные власти немедленно пообещали за два ближайших года соорудить 32 новых коммунальных объекта.
А в Красноярске в самом начале февраля неожиданно . Как позже оправдывалась коммунальная компания "Краском", шёл ремонт на водозаборе. А когда вода в кране снова появилась, она оказалась зеленоватой, со странным запахом и не самым приятным вкусом. В одной из пострадавших семей подчеркнули, что водопроводную воду не пьют, но это не помогло: ребёнок всё равно отравился. Родители полагают, что ему оказалось достаточно почистить с этой водой зубы и принять душ. В общей сложности 92 человека заразились кишечной инфекцией.
Бактерии Shigella. Фото © Shutterstock
Меж тем российских регионов с самой некачественной водой. Первое место в этом списке заняла Свердловская область. Как пояснили в ведомстве, там за последние восемь лет зафиксировали больше всего случаев высокого и экстремально высокого загрязнения воды. В десятке "лидеров" по количеству неутешительных данных проб воды оказались также Архангельская, Владимирская, Ленинградская, Новгородская области и Москва. В отчёте также упоминаются Кировская, Кемеровская, Нижегородская и Пензенская области.
В общей сложности около 30–40% россиян вынуждены регулярно пользоваться водой, не соответствующей гигиеническим требованиям, сообщает Счётная палата. По мнению её специалистов, самая главная проблема водоснабжения в стране — сброс неочищенных или недостаточно очищенных сточных вод. В ведомстве посетовали, что механизмы предоставления разрешений на сброс не мотивируют промышленность и сельское хозяйство сокращать объёмы сливаемых вредных веществ. Счётная палата заявила о намерении направить правительству страны письмо с предложением обеспечить крупным городам (свыше 500 тысяч жителей) финансирование на модернизацию коммунальной инфраструктуры.
Россиянам же в ожидании этого чуда пока что остаётся только самостоятельно проводить анализ того, что льётся из крана, на вкус, запах и цвет.
Если вода…
— Качественной воду централизованного водоснабжения можно считать лишь такую, которая, по мнению потребителей, не имеет запаха, вкуса и привкуса, — "Вода питьевая. Методы определения запаха, вкуса и мутности".
В документе, правда, не описано, какова на запах и цвет вода с кишечной инфекцией. Но перечислены определённые признаки, по которым можно распознать в водопроводе постороннюю жизнедеятельность и вредные вещества:
- "гнилостный", "рыбный" или "травяной" запах означают, что в воде плавают разлагающиеся растения;
- "землистый", "затхлый", "плесневый" запах — признак наличия в воде грибков и плесени;
- запах сероводорода ("тухлых яиц") — результат деятельности сернистых бактерий;
- металлический привкус — "симптом" присутствия соединений тяжёлых металлов;
- лекарственный или химический запах бывает у воды, перемешанной со сточными промышленными отходами.
Кроме того, по другим источникам, идущая по оцинкованным трубам и богатая сульфатами вода часто "горчит", от контакта с пластиком приобретает характерный "резиновый" душок, а сладковатой становится из-за органических веществ, а ещё кальция и магния.
Способы очистки воды на водопроводных станциях

- Отстаивание. Вода в течение нескольких часов стоит в огромных ёмкостях так, чтобы движения в них почти не происходило. Самые крупные и тяжёлые загрязнители выпадают в осадок, их сливают.
- Фильтрация. К примеру, фильтры с активированным углём используют для устранения органики и микробов, а в "умягчающих" содержится смола, которая впитывает кальциевые и магниевые соединения.
- Обратный осмос. Вода пропускается сквозь мембрану под сильным давлением. В результате задерживаются соли, делающие воду жёсткой, железо, а в случае наномембран — даже вирусы и бактерии, потому что такие фильтры не пропускают ничего крупнее молекул воды и кислорода.
- Обеззараживание. В мире для этого используют три вещества: хлор, фтор и озон. В США воду фторируют, в России же предпочитают хлор и иногда (для небольших объёмов воды) — озонирование.
- Коагуляция. Это добавление в воду специальных реагентов, благодаря которым вредные примеси в воде "слипаются" в хлопья и выпадают в осадок.
- Аэрация. Вода обрабатывается воздушной смесью, подаваемой под большим напором. В результате кислород из воздуха окисляет железо и другие ненужные в воде вещества, после чего их становится проще удалить.
- Электродиализ. Под действием электрического поля в воде положительно и отрицательно заряженные ионы начинают двигаться в противоположных направлениях, у них на пути возникают мембраны. Одни мембраны пропускают только катионы, другие — только анионы. В результате можно получить из одной воды два разных типа растворов — один обессоленный, а другой, наоборот, концентрированный. По этому же принципу можно очищать сточные воды и снова извлекать из них нужные для промышленности вещества.
- Биологическая очистка. Речь идёт о погружении в воду полезных микроорганизмов, которые уничтожают органические загрязнения. Это основной этап очистки сточных вод.
Есть довольно много других способов водоподготовки, но они сравнительно редко используются (в основном из-за дороговизны или сложности технологии): облучение воды ультрафиолетом, обработка ультразвуком и даже электрическими разрядами для обеззараживания.
Где можно смело пить из-под крана?

Станция водоочистки в Дании. Фото © Shutterstock
Типичная водоочистная станция в Дании. Почти все они работают по третичной системе: механическая очистка (фильтрация), биологическая (с помощью полезных микробов) и химическая. Но начать стоит с того, что там перерабатывают 68% отходов, а на очистку попадает 99% сточных вод. При этом практически все очистные сооружения муниципальные, редким предприятиям позволено очищать свои стоки самостоятельно. Интересно упомянуть и то, что у очень немногих жителей этой страны дома есть ванна. Датчане берегут свою воду.
В Германии за качеством водопроводной воды следят более тщательно, чем за качеством бутилированной. Система водоснабжения там принадлежит исключительно государству, частным коммунальным предприятиям такое дело там не доверяют. Зато и стакан воды немцу обходится в четыре с лишним раза дороже, чем россиянину.

Питьевой фонтанчик в Риме. Фото © Shutterstock
И наконец, настоящее чудо — знаменитые фонтанеллы и nasoni ("носики") в Риме, спасающие от жажды и делающие счастливыми всех страждущих совершенно бесплатно. Трудно поверить, но вода в них до сих пор , построенным в античные времена. Она спускается с гор Сабатини, расположенных к северо-западу от Вечного города. Там, в частности, находится вулканическое озеро Браччано, которое служит одним из важнейших источников питьевой воды в Италии. Известно, что акведуки сооружались так, чтобы вода проходила сквозь естественные фильтры из песка, угля и травы. Качество воды из питьевых фонтанчиков проверяют ежедневно, и не только специалисты в лабораториях, но и бесчисленные горожане и туристы. Никаких проблем нет: чистая, неизменно холодная и вкусная вода. Кстати, не так давно учёные установили, что вкус воды на языке определяют рецепторы кислого, а в гипоталамусе есть специальные , которые посылают организму сигнал о том, что нужна вода.
Комментарии